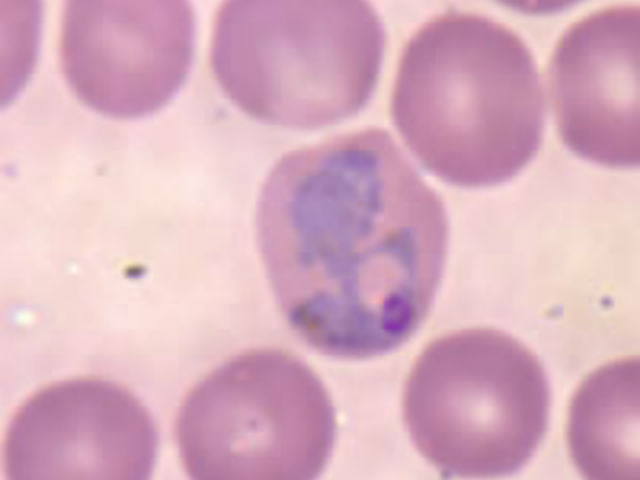
Эритроциты, заражённые паразитом-переносчиком малярии (фото Wikimedia Commons).

Переносчики малярии манипулируют запахом жертвы
Малярию у человека и других животных вызывают паразиты. Заболевание от особи к особи передают переносчики инфекций, например, комары. Комар вместе с кровью проглатывает паразита, и тот создаёт потомство в кишечнике насекомого. Закончив свои дела, паразит переходит по слюнным железам комара к телу нового хозяина.
Учёные выяснили, что паразиты после попадания в тело хозяина меняют его запах. На новый аромат слетаются комары, которые ранее могли проигнорировать потенциальную жертву. Они становятся невольными распространителями потомства паразита.
"Мы обнаружили, что мыши, заражённые малярией, являются более привлекательными для комаров, чем не инфицированные особи. Больше всего они привлекают переносчиков инфекции в тот период, когда хозяйский организм является наиболее заразным", — рассказывает ведущий автор исследования Марк Мешер (Mark Mescher) из университета Пенсильвании.
Авторы новой работы предлагают по запаху определять наличие у пациента инфекции.
"В первую очередь нам были интересны те пациенты, которые уже были инфицированы, но их болезнь протекала бессимптомно. Такие люди могут и дальше передавать заболевание, поэтому нам необходимо разработать диагностический тест для выявления бессимптомной малярии", — поясняет ещё один автор исследования Консуэло Де Мораэс (Consuelo De Moraes), также сотрудник университета Пенсильвании.
В статье, опубликованной в журнале PNAS, исследователи сообщают, что вне зависимости от наличия или отсутствия симптомов, заражённые малярией мыши становились наиболее привлекательными для комаров.
Выявив эту закономерность, Мешер и его коллеги решили вычислить конкретные химические изменения в организме грызунов, которые были вызваны заражением малярией. Были исключены другие факторы, такие как производство двуокиси углерода и увеличение температуры тела.
"Очевидно, что весь процесс распространения заболевания протекает на химическом уровне. Комар не согласился бы просто так переносить паразитов, поскольку они могут повредить его кишечник, слюнные железы или другие органы. Значит, в заражённом организме его инстинктивно привлекает что-то ещё", — сообщает де Мораэс в пресс-релизе.
Работа над вычислением отдельных химических составляющих запаха по-прежнему ведётся. Скорее всего, вещества, выделяемые больными малярией, схожи по аромату с особями противоположного пола у комаров, или напоминают им запахи веществ, необходимых для питания насекомых. В дальнейшем учёные планируют разработать систему биомаркеров для выявления носителей, а также создать простой тест для идентификации малярийных запахов.
Также по теме:
Малярийных комаров заставили отказаться от самок
Генетически модифицированные комары потеряли вкус к людям
Энтомологи придумали, как сделать людей непривлекательными для комаров
Новая вакцина от малярии для детей прошла испытания на мышах
Микроскоп из бумаги поможет снизить смертность от малярии